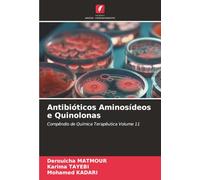
Antibióticos Aminosídeos e Quinolonas: Compêndio de Química Terapêutica Volume 11

- 1
- 2
- 3
- página siguiente
🤖 Pregunta a ChatGPT
Información acerca de "compendio de medicina"
Aquí puedes confrontar el precio de venta online para tu búsqueda de "compendio de medicina" y así encontrar la mejor oferta.
De acuerdo con tu búsqueda "compendio de medicina", hemos encontrado el producto que te interesa en 28 categorías.
Datos de "compendio de medicina"
- El producto que buscas, "compendio de medicina", está disponible en 2 tiendas virtuales, como Amazon Marketplace (ES) y amazon.es.
- Comparar.net ha encontrado 2 tiendas virtuales que ofrecen este producto. Destacan tiendas virtuales como Amazon Marketplace (ES) y amazon.es.
- 4 proveedores ofrecen el producto buscado - Por ejemplo, Elsevier, Springer Verlag, Mandala Eco de Luxe y Maxtor.
- Nuestros clientes han consultado las ofertas siguientes: .
- El número de opciones también es grande a la hora de elegir el color: De entre los 0 colores disponibles, puedes seleccionar tu favorito. El mayor número de ofertas está disponible en .